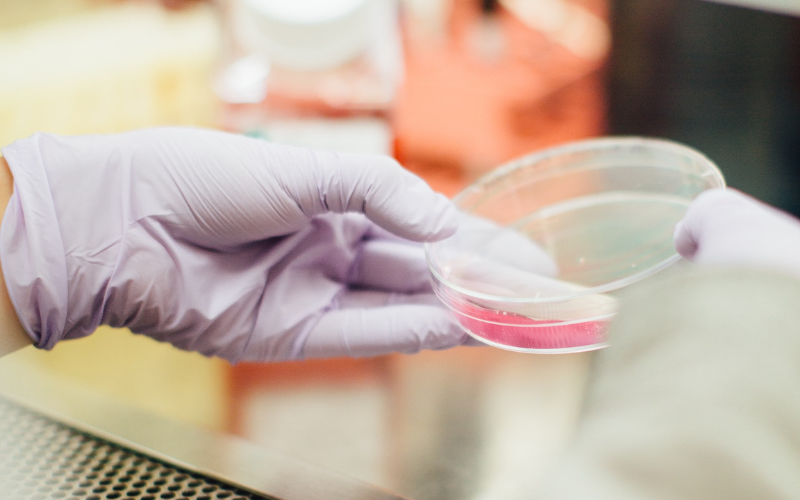

5 Tips To Find The Most Reliable Diesel Supplier In Dubai, UAE.
Few Things You Should Consider Before Choosing One
We have arrived in an era which is driven by technology and innovation. No matter where we live or what our expertise is, fuel is the backbone.
Talking about the UAE in particular, petroleum is available here in abundance i.e. you’ll find a lot of the dealers that supply diesel, petrol etc.
The question is where should one get it from? What are the parameters one should consider while looking for the dealers? Out of hundreds of diesel dealers in the UAE, which one should we select?
In this blog, I’ll be briefing you about a few things we should consider before choosing a diesel distributor in UAE so that you don’t regret after purchasing it for your car, home or office.
Below written are some points you should check and keep in mind before finalizing a diesel supplier in UAE.
1) Decent Service Record.
A good service record is a must for any company whether dealing with the products or services.
Before you give the supply contract to any company, make sure to check their service record. There are a number of ways of doing so. You can check their ratings on the internet or may come in contact with any of their existing or ex-customers. This’ll help you know their credibility and hence picking the right diesel supplier in the UAE.
Not just this, after you purchase you’ll get to know about how their services are after you purchase something from them. That’s equally important. Make sure to choose the diesel supplier who gives a good service too.
2) Genuine Prices.
This is something which can be used as an easy definer of someone’s genuineness and credibility. I mean if you see someone is giving a certain product at a genuine price, he is more likely to earn your trust and the contract too.
Now the question is how can you say if the prices are genuine or not? The answer is simple. Compare it with other distributors and see if the rate is lesser or higher than them. It helps you make a better selection.
3) Product Quality.
Make sure that you get the product quality checked by some expert. Different products can be checked using different methods and tools.
As far as the diesel goes, you can check its quality using a simple method – W-5 Test Kit: This is a test for Water in the diesel fuel.
The process involves simply removing the capsule and adding fuel to the test tube then in seconds you know if water is in the fuel. Any detection of suspended water turns pink and the fuel fails. Make sure that you go with the diesel distributor who supplies the best quality diesel.
4) Efficient Transport.
This point might not be valid for every business but as far as the petroleum industry goes, this is the must have feature.
I mean you can’t have a less efficient transport system while you are running a diesel supplying company. If you are looking for a good diesel supplier make sure that they have a satisfactory transport system. This’ll make it accessible for you whenever you need it hence making it easier for you to get the consignment delivered.
5) Emergency Services.
Last but not the least make sure that the company you are choosing for the diesel supply serves in times of emergency.
It often happens that you run out of fuel in the middle of an operation and you need to refuel it on an emergency basis. In this scenario, you can only count on the company who is reliable enough, has got stocks and understands the emergency. Make sure that you talk to the company prior to giving them the contract.
These were some of the points one must keep in consideration before employing any diesel supplier in the Dubai, UAE. Make sure to check all these boxes before making your final call.
Feel free to contact Globalexuae : a leading diesel supply company in UAE for any queries.
Also Read: How To Find Cost-Effective Freight Forwarding Services In Dubai?